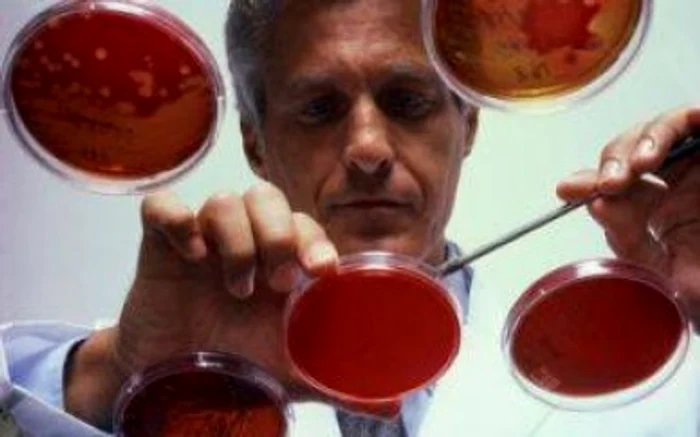
1 2 jpg jpeg

Plante care subţiază sângele
Minunile plantelor naturii au demonstrat cu timpul că sunt de multe ori mai eficiente decât medicina alopată. Sunt plante pentru fiecare afecţiune în parte, plante care fac bine doar unor părţi din organism şi plante care fac bine întregului organism. Aşa sunt urzica şi sulfina, cele mai bune plante care subţiază sângele, îl curăţă şi astfel reduc riscul dezvoltării unor boli grave, precum leucemia sau alte boli asociate cu circulaţia greoaie a sângelui.
Plante care subţiază sângele – Urzica
Cei care au avut ocazia să meargă în vacanţe la ţară, probabil îşi mai aduc aminte de vreo bunică sau străbunică cum se lăsa “muşcată” de urzici. Femeile ar trebui să cunoască efectele minunate ale acestei plante atât asupra aparatului reproducător (fiind tratament sigur pentru dureri menstruale şi probleme cu rinichii), cât şi asupra circulaţiei, curăţând şi subţiind sângele. A te urzica înseamnă să ajuţi sângele să circule mai bine, iar bătrânele de la sat ştiu că dacă se urzică scap de neplăcutele varice, care apar spre bătrâneţe.
Urzica are efect curativ pentru întreg organismul, de la rădăcină, continuând cu tulpina, frunzele, apoi florile, această plantă este cu adevărat tămăduitoare. Planta cu totul conţine glucide, proteine, lipide, steroli, amine, flavonoide, acizi, cetone, ulei volatil, siliciu, zinc şi complex de vitamine (provitaminele A, B2, C, K).
Rădăcina acestei plante care subţiază sângele conţine substanţe de natură glucidică, acizi graşi, polizaharide, amine, acid formic şi acetic, acid folic, clorofilă, substanţe de natură proteică, conţinând un număr mare de aminoacizi, beta-caroten, săruri precum fier, magneziu, calciu, siliciu, lectine. Având acţiune anti inflamatoare, diuretic-depurativă, dar şi vasoconstrictoare, urzica stimulează circulaţia sângelui, şi stopând micşorarea diametrului vaselor sanguine, care duc la reducerea afluxului de sânge.
Spălăturile şi băile cu urzică sunt foarte recomandate pentru orice spasm, care indiferent de unde provine induce tulburări ale irigaţiei sanguine. Pentru persoanele mai curajoase, din iunie, când apar urzicile, până toamna târziu se pot lăsa “muşcate” de urzici pe mâini, picioare. Nu este cea mai plăcută senzaţie, dar sigur au un efect extraordinar.
Oricum, este bine să se facă o cură de primăvară sau toamnă cu această plantă. Băută ca ceai, făcută mâncare sau folosită proaspătă direct pe piele, urzica este excelentă pentru funcţionarea echilibrată a întregului organism. Este folosită cu succes în problemele legate de căderea părului, tot datorită puterii ei de a pune sângele în circulaţie, astfel părul începe să crească din nou.
Plante care subţiază sângele – Sulfina
Sulfina, plantă mai puţin cunoscută, conţine melilotină, acid melilotic şi acid melilotincumarinic. Din melilotzidă se formează cumarină, care imprimă materiei prime miros foarte plăcut, aromatic.
Alte substanţe conţinute de această plantă sunt flavonozide, colină, acid alantonic, ploiholozide, acizi fenolici.
Extractele pe bază de sulfină au acţiune în special diuretică şi de creştere a debitului venos şi limfatic, dar şi antispastică, anti inflamatoare şi anticoagulantă. De asemenea, stimulează sistemul reticulo-endotelial şi scade permeabilitatea capilară.
Sulfina se foloseşte mai ales ca remediu în icter, varice, tulburări circulatorii, tromboflebite, fragilitatea vaselor capilare superficiale. De altfel, se utilizează şi ca aromatizant în diferite produse.
























